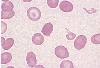

|    |

全登録症例数:225
全登録画像数:1755
全登録画像数:1755
多血球系異形成を伴うAML(AML with multilineage dysplasia)は
骨髄にて骨髄芽球が20%以上を占め、巨核球を含む2系統以上の形態異常(dyspasia)が各々50%以上認めるものを指す。
三血球(系統)の形態異...
(続きを読む) 多血球系異形成を伴うAML(AML with multilineage dysplasia)は
骨髄にて骨髄芽球が20%以上を占め、巨核球を含む2系統以上の形態異常(dyspasia)が各々50%以上認めるものを指す。
三血球(系統)の形態異常(異形成)として次のものがあげられる。
1)顆粒球系:①低顆粒の好中球、②低分葉(偽ペルゲル核異常)など。
2)赤芽球系:①巨赤芽球様変化、②核融解や断片化、③多核、④環状鉄芽球、⑤PAS染色陽性など。
3)巨核球系:①微小巨核球、②単葉または分断された核をもつなど。
本例は薬剤の使用によるものやMDS期の病態もなく、末梢血、骨髄の芽球が20%以上と形態異常が50%以上のことより多血球異形成を伴うAML(AML with multilineage dysplasia:AML-MTD)と診断された。
(たたむ)
骨髄にて骨髄芽球が20%以上を占め、巨核球を含む2系統以上の形態異常(dyspasia)が各々50%以上認めるものを指す。
三血球(系統)の形態異...
(続きを読む) 多血球系異形成を伴うAML(AML with multilineage dysplasia)は
骨髄にて骨髄芽球が20%以上を占め、巨核球を含む2系統以上の形態異常(dyspasia)が各々50%以上認めるものを指す。
三血球(系統)の形態異常(異形成)として次のものがあげられる。
1)顆粒球系:①低顆粒の好中球、②低分葉(偽ペルゲル核異常)など。
2)赤芽球系:①巨赤芽球様変化、②核融解や断片化、③多核、④環状鉄芽球、⑤PAS染色陽性など。
3)巨核球系:①微小巨核球、②単葉または分断された核をもつなど。
本例は薬剤の使用によるものやMDS期の病態もなく、末梢血、骨髄の芽球が20%以上と形態異常が50%以上のことより多血球異形成を伴うAML(AML with multilineage dysplasia:AML-MTD)と診断された。
(たたむ)
■症例詳細データ
| 性別 | 男 |
|---|---|
| 年齢 | 75-79 |
| 取得年代 | 2000-2004 |
| 主訴 | 微熱、倦怠感、食欲不振。 |
| 既往歴 | 特になし。 |
| 現病歴 | 倦怠感、食欲不振にて来院し、貧血を指摘され血液像にて芽球が15%みられたことより当科へ入院となった。 |
| 検査所見 | WBC 2,500/μl(芽球15%) RBC 204万/μl、Hb 7.4g/dl、Ht 22.3%、 MCV 109.3fl、MCH 36.2pg、MCHC 33.2%、PLT 22.3万/μl、NCC 70.3万/μl、MgK 91/μl(芽球60.2%, Ebl.2/100w)PT 72.1%、APTT 34.2sec、Fibg 324mg/dl、D-ダイマー 1.2μg/ml、TP 7.5g/dl, AST 14IU/l, ALT 10IU/l, BUN 16.0mg/dl |
| 末梢血所見 | 白血球減少(2,500/μl)にて芽球が15%で赤芽球もみられた。 周囲には奇形赤血球、標的赤血球、赤血球の2相性、巨大血小板や巨核球がみられた。 |
| 骨髄所見 | 過形成像にて赤芽球が24%より芽球は全有核細胞(ANC)中の60.2%にみられた。 背景には3系統に異形成がみられ、顆粒球系には顆粒の逸脱、偽ペルゲル核異常、PO陰性の好中球がみられ、赤芽球系には巨赤芽球様、多核、変形核がみられ、巨核球系には小型、単葉核、核分離異常の巨核球がみられた。 |
| 細胞化学所見 | 芽球はPO染色に10%が陽性であった。 PAS染色では成熟赤芽球系にび慢性の陽性がみられ、Fe染色では環状鉄芽球が68%みられた。 |
| 形態診断 | 末梢血は白赤芽球症で、骨髄は芽球が60.2%みられたこと、3系統に顕著な異形成(形態異常)が50%以上(WHOでは2系統以上において各々50%以上)みられたことより、多血球異形成を伴うAMLを疑った。しかし、3系統の異形成が顕著なため、MDSから急性転化したことや化学療法後のことも考慮する必要があった。 |
| 免疫学的所見 | CD13・CD33・CD34・HLA-DR(+) |
| 分子生物学的所見 | 46,XY [20] |
| リンパ節所見 | 未施行。 |
| 臨床診断 | 本例は薬剤の使用によるものやMDS期の病態もなく、末梢血、骨髄の芽球が20%以上と形態異常が50%以上のことより多血球異形成を伴うAML(AML with multilineage dysplasia:AML-MTD)と診断された。 顕著な三系統の異形成にも関わらず染色体は正常の核型であった。 |